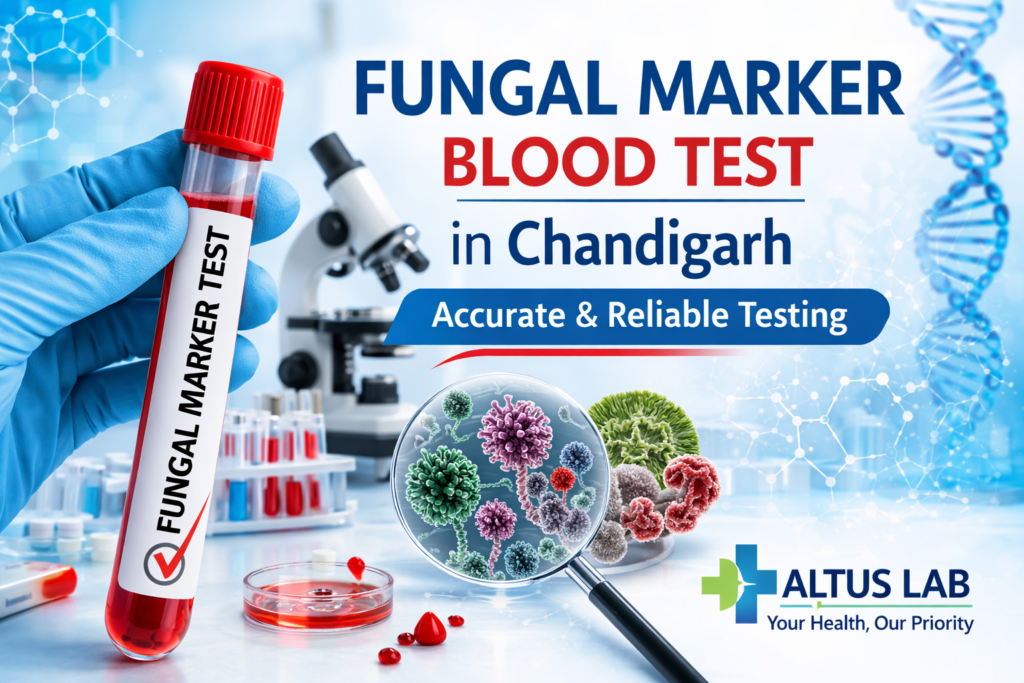
Fungal Marker Blood Test In Chandigarh At Altus Lab For Detecting Systemic Fungal Infections

If you are looking for a fungal marker blood test in Chandigarh, Altus Lab offers specialist Galactomannan (GMI) and Beta-D-Glucan (BDG) testing with free home collection across Chandigarh, Mohali, and Panchkula. Invasive fungal infections – particularly Aspergillosis and Candida – are a leading cause of life-threatening illness in immunocompromised patients. Because clinical symptoms overlap with bacterial infection and conventional cultures can take days to weeks and are often negative, non-culture-based fungal biomarkers are now the international standard for early diagnosis.
Our lab is founded and led by an Ex-PGIMER Chandigarh doctor with over 13 years of specialist diagnostic experience. Altus Lab’s in-house infectious disease panel includes both GMI and BDG assays, processed on-site with strict quality controls. Doctors at PGIMER’s haematology, pulmonology, and ICU departments – as well as Fortis Mohali and Max Hospital – accept our fungal marker reports for urgent clinical decision-making.
What Are GMI and Beta-D-Glucan?
| Marker | Full Name | What It Detects | Normal Range |
|---|---|---|---|
| GMI | Galactomannan Index | Cell wall polysaccharide released by Aspergillus species during active infection | <0.5 ODI (optical density index) – negative |
| BDG | Beta-D-Glucan (1,3-ฮฒ-D-Glucan) | Cell wall component present in most pathogenic fungi including Candida, Aspergillus, and Pneumocystis jirovecii | <60 pg/mL – negative; 60โ79 pg/mL – indeterminate; โฅ80 pg/mL – positive |
When Are Fungal Markers Used?
Fungal markers are used for two primary purposes – early diagnosis of invasive fungal infection and monitoring of antifungal treatment response. Because culture-based diagnosis is slow and insensitive for invasive fungal infections, GMI and BDG allow clinicians to start antifungal therapy days earlier than would otherwise be possible. In critically ill and immunocompromised patients, this earlier treatment consequently translates directly into improved survival.
Who Should Get a Fungal Marker Test in Chandigarh?
- Haematology patients on chemotherapy for leukaemia, lymphoma, or multiple myeloma – highest risk group for invasive Aspergillosis
- Bone marrow and stem cell transplant recipients during the neutropenic phase post-transplant
- Solid organ transplant patients on long-term immunosuppression
- ICU patients with prolonged broad-spectrum antibiotic use and central venous catheters – high risk for invasive Candida
- HIV/AIDS patients with low CD4 counts – for Pneumocystis jirovecii pneumonia (PCP) screening via BDG
- Patients on high-dose or long-term corticosteroid therapy
- Patients with unexplained fever, pulmonary infiltrates, or deteriorating respiratory function that fails to respond to antibacterial therapy
- Post-COVID patients with prolonged fever and pulmonary infiltrates – COVID-associated Aspergillosis (CAPA) is a recognised complication
Understanding GMI vs BDG Results
Galactomannan (GMI) – Aspergillus-Specific
GMI is specific for Aspergillus species and is therefore the test of choice when Invasive Pulmonary Aspergillosis (IPA) is suspected. Serial GMI testing every 3โ4 days in high-risk haematology patients is recommended by international guidelines (ESCMID, IDSA). A single positive GMI in serum requires confirmation with a second sample or BAL (bronchoalveolar lavage) GMI testing. False positives can occur with piperacillin-tazobactam use and in patients receiving certain food products.
Beta-D-Glucan (BDG) – Broad Fungal Screening
BDG detects most medically important fungi including Candida, Aspergillus, and Pneumocystis – but notably not Cryptococcus or Mucor, which do not produce BDG. It is consequently more useful as a broad screening tool. Two consecutive positive BDG results on separate days significantly increase the probability of invasive fungal infection. BDG can be falsely elevated by haemo dialysis membranes, certain surgical gauze products, and albumin infusions.
Why Choose Altus Lab for Fungal Marker Testing in Chandigarh?
- Founded by an Ex-PGIMER Chandigarh Doctor – specialist infectious disease diagnostics
- Both GMI and BDG Available – comprehensive fungal biomarker panel in a single visit
- Urgent Processing for Critical Patients – results prioritised for ICU and haematology patients
- Reports Accepted at PGIMER and Fortis Mohali – supporting life-critical antifungal treatment decisions
- Free Home Collection – across Chandigarh, Mohali, Panchkula, and Zirakpur
Frequently Asked Questions – Fungal Marker Test in Chandigarh
What is the difference between GMI and BDG testing?
GMI is specific for Aspergillus species, whereas BDG detects a broader range of fungi including Candida and Pneumocystis. They are consequently complementary – a patient suspected of Aspergillosis should have GMI; a patient suspected of any invasive fungal infection should have BDG; and a high-risk haematology patient should ideally have both together as a comprehensive fungal screen.
Can this test be done at home in Chandigarh?
Yes. Altus Lab provides free home blood sample collection for GMI and BDG testing across Chandigarh, Mohali, and Panchkula. For urgent cases in the ICU or hospital setting, please call 0172-5017001 directly to arrange priority sample collection and processing.
My haematologist has requested serial GMI monitoring. How often should I test?
International guidelines recommend GMI monitoring every 3โ4 days during the highest-risk neutropenic period in haematology patients. Your haematologist at PGIMER Chandigarh will specify the exact testing frequency based on your clinical situation. Altus Lab can coordinate a scheduled testing programme for such patients.
Book Your Fungal Marker Test in Chandigarh Today
For immunocompromised patients, early detection of invasive fungal infection is life-saving. Book GMI and BDG testing at Altus Lab today – results accepted directly at PGIMER haematology, Fortis Mohali ICU, and all major Tricity specialist centres.
Call Now: 0172-5017001 / 0172-5017002
Available: 7:30 AM โ 9:30 PM Daily
Free Home Collection: Chandigarh | Mohali | Panchkula | Zirakpur
Founded by Ex-PGIMER Doctor | Own In-House Lab | Priority Processing Available

